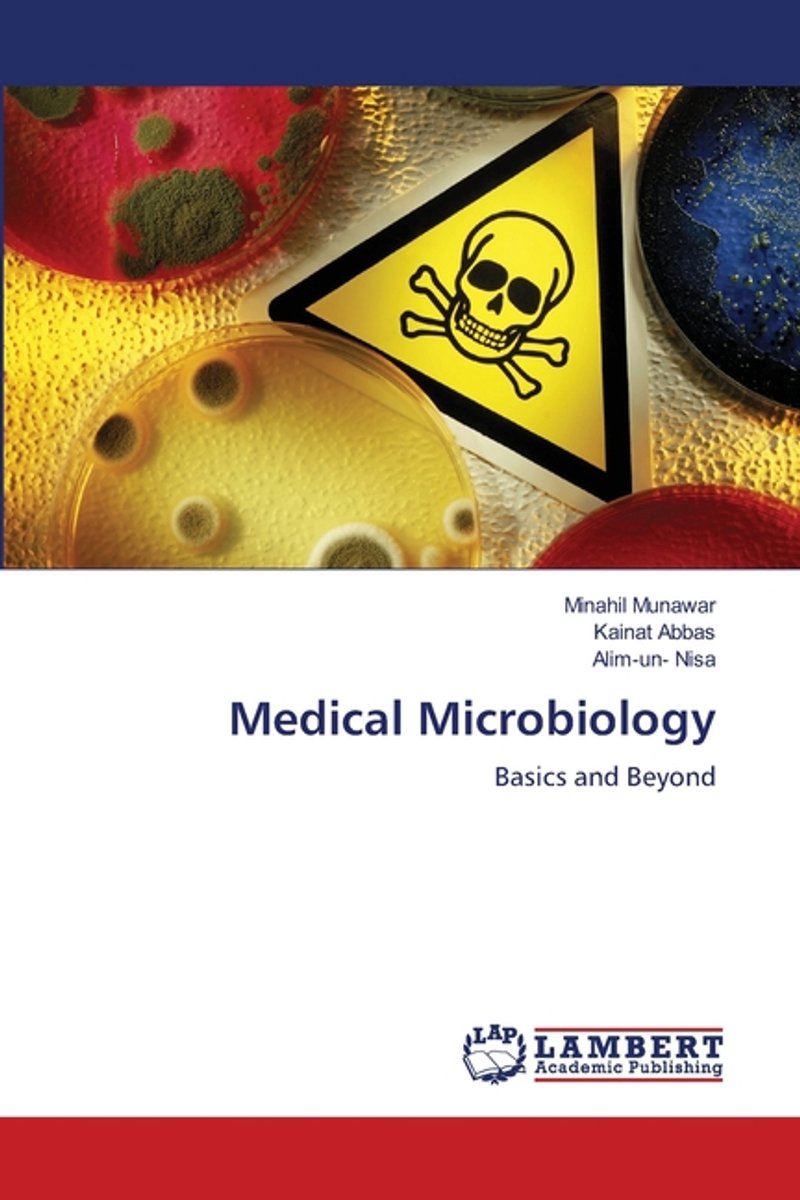

Type: Paperback
ISBN: 9783844329988
Levertijd: 14
Aanbieder: